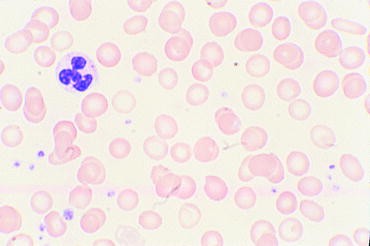

Hereditary Hemochromatosis Vs Wilson Disease Medcomic
bronze diabetes usmle is free HD wallpaper was upload by Admin. Download this image for free in HD resolution the choice "download button" below. If you do not find the exact resolution you are looking for, then go for a native or higher resolution.
Don't forget to bookmark bronze diabetes usmle using Ctrl + D (PC) or Command + D (macos). If you are using mobile phone, you could also use menu drawer from browser. Whether it's Windows, Mac, iOs or Android, you will be able to download the images using download button.
Mike Natter Medical Iron Man Hemochromatosis What If
Anki Soze S Step 1 Master Deck Soze Media
Bronze Diabetes Hemochromatosis Peripheral Neuropathy
Hemochromatosis Gastrointestinal Medbullets Step 1
Hemochromatosis Is A Disease In Which Too Much Iron Builds
Hereditary Hemochromatosis Vs Wilson Disease Medcomic
Hemochromatosis Bronze Diabetes Symptoms Diagnosis
Uworld 7 4 17 Flashcards Quizlet
Mystery Of Bronze Diabetes Pathophysiology Diagnosis And
Hereditary Hemochromatosis Vs Wilson Disease Medcomic
Hfe Hereditary Haemochromatosis Wikipedia
Usmle Complete Gold Collection
Hereditary Hemochromatosis Genetics Home Reference Nih
A 62 Year Old Man With Fatigue Joint Pain And Bloating
Usmle Step 1 Peptic Ulcer Esophagus
Hereditary Hemochromatosis Genetics Home Reference Nih
Usmle Step 2 Ck At University Of North Texas Health Science
First Aid Cases Usmle1 3rd Ed By L C Diaz Issuu
H 1pat4 Iron Overload Heme Flashcards Memorang
Here S The Most Missed Usmle Test Prep Question And The
Full Text Autoamputation Of Diabetic Toe With Dry Gangrene
Clinical Review For The Usmle Step 1 By Surgisphere Issuu
Step 2 Ck Bible Hemorrhoid Breast Cancer
Usmle Step 2 Secrets Digitalbookocean Info
Usmle Step 1 First Aid Rapid Review And Step Up Crunch Time
Clinical Review For The Usmle Step 1 By Surgisphere Issuu
Diabetes Mellitus Osmosis Video Library
Skin Manifestations Of Diabetes Mellitus Endotext Ncbi
Usmle Pathognomics Kidney Disease Cancer
Diagnosis And Management Of Hemochromatosis 2011 Practice
Alkaptonuria Ar Disorder Of Tyrosine Metabolism Def Of
2012 Pediatrics And Children 1
Diagnosis And Management Of Hemochromatosis 2011 Practice
Bible 3rd Edition Usmle Success Academy
Diabetes Mellitus Endocrine Medbullets Step 2 3
Level 4 Usmle Medicine 2018 Memrise
Silver Linings Usmle Step 1 Preparation
Full Text Autoamputation Of Diabetic Toe With Dry Gangrene
30 Useful Points You Need To Sort Out About Hemochromatosis
Usmle Step 2 Ck Lecture Notes Docsity
Skin Manifestations Of Diabetes Mellitus Endotext Ncbi
Usmle Tutors Usmletutors Twitter
Pdf United States Medical Licensing Examination Usmle Step
2019 First Aid For The Usmle Step 1
How To Score Above 270 On The Usmle Elite Medical Prep
30 Useful Points You Need To Sort Out About Hemochromatosis
Personal Writing In The Classroom Life Writing Essays And
Gi 1 Usmle With Oio At Harvard Medical School Studyblue
B Thalassemia Major Homozygote B0 B0 Description Usmle
Hereditary Hemochromatosis Genetics Home Reference Nih
Hereditary Hemochromatosis Vs Wilson Disease Medcomic
Clinical Review For The Usmle Step 1 By Surgisphere Issuu
Goljan Hepatobiliary And Pancreatic Rapid Review Ch 19
Term Weils Disease Definition Leptospirosis Term Wermers
Personal Writing In The Classroom Life Writing Essays And
Usmle Gi Part 1 P Flashcards Memorang
Diabetes Excessive Hunger No 1 Of 10 Type 2 Diabetes Signs And Symptoms
Usmle Step 2 Ck Lecture Notes Docsity
Usmle题库hepatic21 30 4 6 图文 百度文库
Full Text Autoamputation Of Diabetic Toe With Dry Gangrene
Prepare For Medical Exams July 2017
Hemochromatosis For All Instagram Posts Publicinsta
Tuberculosis A Complete Review For The Usmle Medrx
Personal Writing In The Classroom Life Writing Essays And
Pdf Human Genome And Chromosomal Abnormalities Genetics
Primary Biliary Cholangitis Gastrointestinal Medbullets
P Chakravarti Pchakravarti Twitter
Kaplan Ln S 2 Ck Pediatrics 2013
Hfe Hereditary Haemochromatosis Wikipedia
Physician Advocacy American Medical Association
Biostatistics Summary Step 1 The Basics Usmle Youtube
Pathology Of The Liver Flashcards Quizlet
A Rare Case Of Hemochromatosis And Wilson S Disease
Usmle Step 2 Ck Lecture Notes Docsity
Hemochromatosis For All Instagram Posts Publicinsta
Usmle World Wrong Questions At University Of California
Anki Soze S Step 1 Master Deck Soze Media